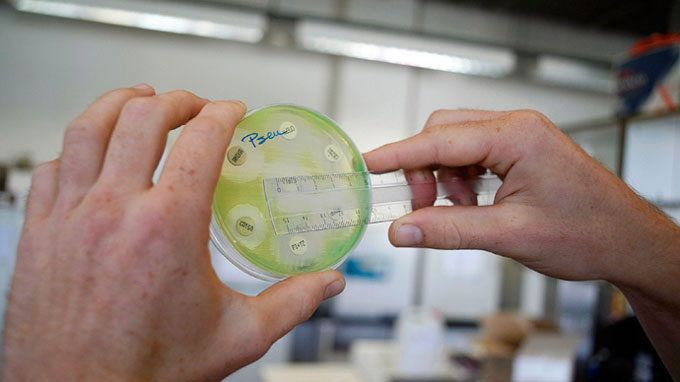

Theo ước tính của Tổ chức Y tế thế giới (WHO), mỗi năm thế giới có khoảng 9,6 triệu người mắc bệnh lao, trong đó 13% mắc lao đồng nhiễm HIV. Trong các bệnh truyền nhiễm, bệnh lao đứng hàng tử vong thứ 2 với khoảng 1,3 triệu người chết do lao, trong đó khoảng 510.000 phụ nữ. Việt Nam đứng hàng thứ 12 trong 20 nước có gánh nặng bệnh lao cao nhất toàn cầu và 14 trong 27 nước có bệnh lao đa kháng thuốc (MDR-TB) nặng nhất thế giới.
Bệnh lao (Tuberculosis_TB) là bệnh truyền nhiễm do vi khuẩn lao(Mycobacterium tuberculosis) gây ra, nhiều nhất là lao phổi lây truyền từ người này sang người khác thông qua những hạt nước nhỏ bắn ra từ họng và phổi của người có bệnh lao phổi thể hoạt động (active respiratory disease).Ở người khỏe mạnh, việc nhiễm vi khuẩn lao thường không gây triệu chứng do hệ miễn dịch cơ thể tạo phản ứng ngăn chặn (wall off) vi khuẩn. Triệu chứng thường gặp của lao phổi thể hoạt động bao gồm ho, đôi khi kèm theo đờm hoặc máu, tức ngực, mệt mỏi, sút cân, sốt hoặc ra mồ hôi ban đêm. Bệnh lao điều trị được bằng kháng sinh theo liệu trình 6 tháng (six-month course of antibiotics).

Bệnh lao (TB) là bệnh truyền nhiễm do vi khuẩn lao (Mycobacterium tuberculosis) gây ra
Báo cáo toàn cầu về bệnh lao
Theo Báo cáo của WHO về bệnh lao toàn cầu năm 2016 (Global Tuberculosis Report 2016), chấm dứt dịch bệnh lao toàn cầu (end the global TB epidemic) là một trong những mục tiêu phát triển bền vững (SDGs) đến năm 2030 đã được Liên Hiệp Quốc (UN) thông qua năm 2015. Chiến lược chấm dứt bệnh lao (End TB Strategy) của WHO đã được Hội đồng Y tế thế giới (WHA) phê duyệt trong năm 2014, kêu gọi giảm 90% tử vong TB và giảm 80% mắc bệnh lao vào năm 2030 so với năm 2015. Báo cáo bệnh lao toàn cầu 2016 lần đầu tiên được phát hành trong kỷ nguyên SDGs và Chiến lược chấm dứt bệnh lao của WHOcung cấp đánh giá toàn diện về dịch bệnh lao và tiến bộ trong chẩn đoán, điều trị và phòng chống lao cũng như góc nhìn tổng quan về các nguồn đầu tư tài chính và nghiên cứu bệnh lao; đồng thời thảo luận về chương trình nghị sự rộng lớn hơn của bảo hiểm y tế toàn dân, bảo hiểm xã hội và các mục tiêu SDGs khác có ảnh hưởng đến sức khỏe.Dữ liệu trong báo cáo của WHO có sẵn cho 202 quốc gia và vùng lãnh thổ, chiếm hơn 99% dân số và các trường hợp mắc lao trên thế giới (world’s population and TB cases).

Lao phổi phổ biến nhất trong tất cả các trường hợp nhiễm lao
Gánh nặng bệnh lao toàn cầu
Trên thế giới, WHO cho biết bệnh lao là nguyên nhân gây tử vong do tác nhân truyền nhiễm đơn (single infectious agent) lớn thứ hai toàn cầu sau HIV/AIDS, thống kê của WHO năm 2010 trên thế giới có 8,8 triệu người bị bệnh lao và 1,4 triệu người tử vong do lao, trong đó Việt Nam ước tính có khoảng 180.000 ca bệnh lao mỗi năm (199/100.000 dân). Trên 95% số ca tử vong do lao toàn cầu xảy ra ở các nước có mức thu nhập thấp và trung bình, bệnh lao nằm trong số 3 bệnh gây tử vong hàng đầu cho phụ nữ trong độ tuổi từ 15 đến 44. Báo cáo Lao toàn cầu của WHO 2016 cho thấy dịch bệnh TB lớn hơn so với ước tính trước đây qua giám sát và khảo sát dữ liệu mới từ Ấn Độ, tuy nhiên số ca tử vong do lao và tỷ lệ mắc lao tiếp tục giảm trên phạm vi toàn cầu cũng như ở Ấn Độ. Trong năm 2015, ước tính 10,4 triệu ca mắc lao mới (new TB cases)hay hiện mắc (incident) lao trên toàn thế giới, trong đó có 5,9 triệu (56%) là nam giới, 3,5 triệu (34%) nữ giới và 1,0 triệu (10%) trẻ em;những người đồng nhiễm với HIV chiếm 1,2 triệu (11%) của tất cả các trường hợp lao mới. Báo cáo của WHO cho biết 6 quốc gia chiếm 60% các trường hợp lao mới bao gồm Ấn Độ, Indonesia, Trung Quốc, Nigeria, Pakistan và Nam Phi do vậy WHO cho rằng tiến bộ xóa bỏ bệnh lao toàn cầu phụ thuộc vào kết quả tích cực phòng chống lao và mức độ quan tâm đầu tư của các quốc gia này. Trên thế giới, tốc độ giảm mắc bệnh lao vẫn chỉ ở mức 1,5% trong 2 năm 2014-2015 do đó cần được tăng tốc mức giảm hàng năm để đạt tỷ lệ giảm 4-5% vào năm 2020 nhằm tiến tới những cột mốc đầu tiên trong Chiến lược toàn cầu chấm dứt bệnh lao.

Báo cáo toàn cầu bệnh lao năm 2016 của WHO
WHO xác định 30 quốc giacógánh nặng bệnh lao cao nhất bao gồm 20quốc giacó gánh nặng caonhấtcủa bệnh (ước tính số ca nhiễm lao mới mỗi năm): Bangladesh, Brazil, Trung Quốc, Cộng hòa Dân chủ Nhân dân Triều Tiên, Cộng hòa Dân chủ Congo, Ethiopia, Ấn Độ, Indonesia, Kenya, Mozambique, Myanmar, Nigeria, Pakistan, Papua New Guinea, Philippines,Liên bangNga, Nam Phi, Thái Lan, Cộng hòa Thống nhất Tanzania và Việt Nam. 10 quốc gia có tỷ lệmắc mớicao nhất (ước tính số ca nhiễm lao mới/100 000) và ítnhất10.000 ca nhiễm lao mới được ước tính mỗi năm: Angola, Campuchia, Cộng hòa Trung Phi, Congo, Lesotho, Liberia, Namibia, Sierra Leone, Zambia và Zimbabwe. WHO đã xuất bản một cuốn sổ tay nhân ngày thế giới phòng chống lao năm 2016 về những hành động đang được thực hiện trong những nước có gánh nặng bệnh cao nhất.
Vấn đề lao đồng nhiễm (co-infected) HIV và lao đa kháng thuốc MDR-TB là những trở ngại lớn cho Chiến lược toàn cầu chấm dứt bệnh lao của WHO
Vấn đề lao đồng nhiễm (co-infected) HIV và lao đa kháng thuốc MDR-TB là những trở ngại lớn cho Chiến lược toàn cầu chấm dứt bệnh lao của WHO đến năm 2030. Báo cáo của WHO cho biết bệnh lao là nguyên nhân gây tử vong hàng đầu ở người có HIV, gây ra khoảng 1/4 tổng số ca tử vong ở nhóm người này, cùng với lao kháng đa thuốc (Multi-drug resistant TB_MDR-TB) đã xuất hiện ở hầu hết các quốc gia được khảo sát. WHO ước tính số người mắc bệnh lao hàng năm đang giảm dần dù với tốc độ rất chậm cho thấy thế giới đang thực hiện đúng lộ trình đạt đến Mục tiêu phát triển thiên niên kỷ (MDGs) đẩy lùi bệnh lao vào năm 2015.

Gánh nặng toàn cầu về bệnh lao năm 2015
Trong năm 2015, ước tính có khoảng 480.000 trường hợp lao mới đa kháng thuốc (MDR-TB) cộng thêm 100.000 người mắc lao kháng thuốc rifampicin (rifampicin-resistant TB_RR-TB) đồng thời cũng đủ điều kiện điều trị MDR-TB. Đặc biệt là 3 quốc gia bao gồm Ấn Độ , Trung Quốc và Liên bang Nga chiếm gần 50% trong tổng số 580.000 trường hợp MDR-TB và RR-TB. Báo cáo của WHO cho biết có khoảng 1,8 triệu tử vong do lao trong năm 2015, cộng thêm 4 triệu tử vong do lao đồng nhiễm với HIV; mặc dù số ca tử vong do lao đã giảm 22% từ năm 2000 đến 2015 nhưng bệnh lao vẫn là 1 trong top 10 nguyên nhân tử vong hàng đầu trên thế giới năm 2015 cao hơn cả HIV và sốt rét.

WHO/C. Doan
Kết quả chăm sóc và phòng chống bệnh lao
Điều trị bệnh lao đã ngăn chặn 49 triệu ca tử vong do lao trên toàn cầu từ năm 2000 đến 2015 nhưng khoảng cách chẩn đoán và điều trị quan trọng vẫn tồn tại. Trong năm 2015, 6.1 triệu ca lao mới đã được báo cáo WHO và thông báo tới chính phủ các quốc gia. Các trường hợp nhiễm lao thông báo tăng từ 2013-2015, chủ yếu là do sự gia tăng 34% các ca lao thông báo ở Ấn Độ,những lỗ hổng (gaps) trong xét nghiệm lao và báo cáo các trường hợp nhiễm mới vẫn là những thách thức lớn.Trong số 10,4 triệu trường hợp mới được ước tính, chỉ có 6,1 triệu người được phát hiện và ghi nhận chính thức vào năm 2015 tạo ra một lỗ hổng kiểm soát TB cho khoảng 4,3 triệu người do báo cáo các ca mắc lao không đầy đủgiữa các trường hợp hiện mắc và được thông báo (between incident and notified cases); trong đó Ấn Độ, Indonesia và Nigeria chiếm gần 50% lỗ hổng này, đặc biệt là khu vực tư nhân không được kiểm soát và chẩn đoán chặt chẽ ở các nước có những rào cản lớn với tiếp cận dịch vụ chăm sóc bệnh lao,trong khi khủng hoảng phát hiện và điều trị MDR-TB vẫn tiếp tục. Trong năm 2015, WHO ước tính 580.000 ca lao mới đủ điều kiện điều trị MDR-TB nhưng mới chỉ 125.000 ca (20%) được ghi nhận. Báo cáo của WHO cho biết 5 nước chiếm hơn 60% của khoảng cách này bao gồm Ấn Độ, Trung Quốc, Liên bang Nga, Indonesia và Nigeria. Trên toàn cầu, 52% điều trị thành công MDR-TB năm 2013 và 55% số bệnh nhân lao được thông báo có kết quả xét nghiệm HIV năm 2015, tỷ lệ bệnh nhân lao nhiễm HIV đang điều trị kháng virus (ART) là 78%. Tiếp cận với nhu cầu điều trị dự phòng lao được mở rộng,tổng số 910.000 người đồng nhiễm với HIV đã được bắt đầu điều trị như vậy trong năm 2015 cũng như 87.000 trẻ em dưới 5 tuổi (7% trường hợp đủ điều kiện).

Bản đồ dịch tễ học bệnh lao trên thế giới
Để tiến tới mục tiêu tham vọng chấm dứt bệnh lao vào năm 2030, WHO đã huy động nguồn lực tài chính đến 6,6 tỷ đô la (USD) đầu tư cho việc chăm sóc và phòng chống bệnh lao ở các nước có mức thu nhập thấp và thu nhập trung bình vào năm 2016, trong đó 84% là từ nguồn trong nước.Tuy nhiên, các chương trình lao quốc gia (national TB programmes_NTPs) ở các nước có thu nhập thấp tiếp tục dựa vào các nhà tài trợ quốc tế gần 90% nguồn tài chính của họ;đầu tư vào các nước có mức thu nhập thấp và trung bình giảm gần 2 tỷ USD trong 8,3 tỷ USD cần có trong năm 2016. WHO dự báo khoảng cách này hàng năm sẽ mở rộng đến 6 tỷ USD vào năm 2020 nếu mức kinh phí hiện nay không tăng. Cải thiện cần thiết tài chính về y tế chung của các chính phủ trong năm 2014 cũng ít hơn so với dự kiến của WHO tối thiểu 6% tổng sản phẩm trong nước (GDP) tại 150 quốc gia.Các khoản chi trực tiếp bằng tiền mặt (Out-of-pocket) vượt quá 45% tổng chi phí y tế tại 46 quốc gia, trong đó có 11 trong số 30 quốc gia có gánh nặng bệnh lao cao. Nghiên cứu và phát triển TB (TB research and development) mặc dù có một số tiến bộ nhưng vẫn chưa đáp ứng yếu cầu hiện tại. Từ đó, Báo cáo toàn cầu về bệnh lao năm 2016 của WHOnhấn mạnh sự bất bình đẳng đáng kể giữa các quốc gia trong việc hỗ trợ người mắc bệnh lao tiếp cận chẩn đoán và điều trị can thiệp hiệu quả chi phí hiện có mà có thể đẩy nhanh tốc độ suy giảm lao trên toàn thế giới, đồng thời cảnh báo sự cần thiết cam kết chính trị mạnh mẽ và gia tăng tài trợ.
Chiến lược chấm dứt bệnh lao của WHO (The End TB Strategy)
Chiến lược chấm dứt bệnh lao của WHO được WHA thông qua tháng 5/2014 là một kế hoạch chi tiết cho các nước nhằm chấm dứt dịch bệnh lao bằng cách làm giảm tử vong bệnh lao, tỷ lệ mắc mới và loại bỏ các thảm họa chi phí, vạch ra các mục tiêu tác động toàn cầu để làm giảm tử vong do bệnh lao tới 90% và cắt giảm các trường hợp mới tới 80% từ năm 2015 đến 2035 đảm bảo không có gia đình nào phải gánh chịu thảm họa chi phí do bệnh lao. Cụ thể, WHO đề ra chiến lược này với mục tiêu chấm dứt dịch bệnh lao toàn cầu theo SDGs với các chỉ sốgiảm 95% tử vong do lao vào năm 2035 so với 2015; giảm 90% tỷ lệ mắc lao vào năm 2035 so với 2015; không có gia đình bệnh nhân lao phải đối mặt vớithảm họa chi phí điều trị bệnh lao vào năm 2035. Chiến lược vạch ra 3 trụ cột (pillars) cần đạt được nhằm chấm dứt bệnh dịch lao hiệu quả bao gồm lồng ghép dự phòng và lấy việc chăm sóc bệnh nhân làm trung tâm; có các chính sách táo bạo và hệ thống hỗ trợ; tăng cường nghiên cứu và đổi mới. Sự thành công của chiến lược sẽ phụ thuộc vào việc các quốc gia tôn trọng 4 nguyên tắc chính sau đây khi họ thực hiện các biện pháp can thiệp được nêu trong mỗi trụ cột như trách nhiệm và quản lý nhà nước về giám sát và đánh giá (government stewardship and accountability with monitoring and evaluation); liên minh mạnh mẽ với các tổ chức xã hội dân sự và cộng đồng (strong coalition with civil society organizations and communities); bảo vệ và thúc đẩy quyền con người, đạo đức và công bằng (protection and promotion of human rights, ethics and equity); thích ứng với chiến lược và mục tiêu ở cấp quốc gia với sự hợp tác toàn cầu (Adaptation of the strategy and targets at country level, with global collaboration).

Biểu đồ tăng tốc sự giảm tỷ lệ mắc lao toàn cầu với tối ưu hóa các công cụ hiện tại, kết hợp với tiến độ phổ cập y tế và bảo hiểm xã hội từ 2015 và tác động bổ sung các công cụ mới vào 2025
Để đạt được các mục tiêu đề ra trong Chiến lược toàn cầu chấm dứt bệnh lao, mức giảm hàng năm tỷ lệ mắc lao toàn cầu đầu tiên phải được tăng tốc mỗi năm từ 2% (năm 2015) lên 10% (năm 2025); tỷ lệ tử vong do lao phải giảm từ 15% (năm 2015) xuống còn 6,5% (năm 2025). WHO cho rằng tham vọng giảm số ca tử vong và tỷ lệ mắc lao vào năm 2025 cần có tính khả thi với các công cụ hiện có bổ sung bằng bảo hiểm y tế toàn dân và an sinh xã hội. Để duy trì sự tiến bộ vượt 2025, đạt SDGs 2030 và kết thúc bệnh lao vào năm 2035 thì mục tiêu và công cụ bổ sung phải có sẵn từ năm 2025. Đặc biệt, cần có một loại vaccine mới hiệu quả và an toàn để giảm số ca nhiễm lao mới phát sinh từ khoảng 2 tỷ người trên thế giới cùng với chẩn đoán tốt hơn và phác đồ điều trị ngắn hơn đối với bệnh lao, để có được các công cụ mới sẽ vào năm 2025, ngay từ bây giờ các quốc gia cần tăng cường rất nhiều và đầu tư trực tiếp trong nghiên cứu và phát triển theo yêu cầu.

WHO/news releases
Phòng chống bệnh lao ở Việt Nam
Nỗ lực phòng chống lao
Ở Việt Nam, Chính phủ coi hoạt động phòng chống lao là một trong những ưu tiên quốc gia, theo dó Chương trình phòng chống lao Quốc gia (National TB Programme_NTP)được thành lập vào năm 1986 đạt độ bao phủ toàn bộ về địa lý vào năm 2000 là một trong những chương trình thành công nhất về kết quả điều trị với tỷ lệ điều trị thành công các ca bệnh lao (acid-fast bacilli_AFB) dương tính mới liên tục đạt trên 90% từ năm 1998. Tuy vậy, Việt Nam vẫn xếp thứ 12 trong số 20 quốc gia có gánh nặng bệnh lao cao nhất thế giới và xếp thứ 14 trong nhóm 27 quốc gia có gánh nặng bệnh lao kháng đa thuốc (MDR-TB) cao chiếm khoảng 85% số ca bệnh lao kháng thuốc ước tính trên toàn cầu (3.500 ca lao kháng đa thuốc/năm), 7.600 bệnh nhân lao được xác định đồng nhiễm (co-infected) với HIV virus.


MDR-TB in children still prevalent, remain underdiagnosed
Chiến lược DOTS (về điều trị có kiểm soát trực tiếp) được áp dụng từ năm 1992.Theo Bệnh viện Phổi Trung ương, mỗi năm cả nước có khoảng 130.000 bệnh nhân mắc lao mới và số người chết do lao trung bình mỗi ngày khoảng 50 người. Trong năm 2015, tổng số bệnh nhân lao các thể được phát hiện là hơn 100.000 người, trong đó có hơn 50.000 bệnh nhân lao phổi tập trung cao ở các tỉnh miền Nam, đó là chưa kể mới chỉ phát hiện được khoảng 70% số người mắc lao, còn 30% bệnh nhân lao trong cộng đồng chưa được phát hiện. Điều tra hiện mắc lao toàn quốc lần thứ nhất (2006-2007) cho thấy tỷ lệ hiện mắc lao AFB dương tính chung cho mọi lứa tuổi ở mức 145/100.000 dân. Tổ chức Y tế Thế giới ước tính Việt Nam có khoảng 180.000 ca bệnh lao mỗi năm (199/100.000 dân). Từ giữa thập niên đầu của thế kỷ này, tỷ lệ phát hiện lao (các thể) đã giảm khoảng 0,8% và giảm 1,7% một năm đối với các ca bệnh lao AFB dương tính mới.

Phát hiện sớm và điều trị kịp thời bệnh lao ở Việt Nam
Chiến lược phòng chống bệnh lao của Việt Nam
Xuất phát từ quan điểmlao là bệnh truyền nhiễm nguy hiểm với sức khỏe cũng như tính mạng bệnh nhân có nguy cơ lây lan rộng ra cộng đồng; bệnh lao có thể chữa khỏi nếu được phát hiện sớm và điều trị kịp thời vì vậy phòng chống bệnh laolà một nhiệm vụ quan trọng lâu dài của cả hệ thống chính trịtrong đó ngành y tế là nòng cốt; Nhà nước giữ vai tròchủ đạo bảo đảm các nguồn lực cho công tác phòng chống bệnh lao, đồng thời cần huy động mọi nguồn lực xã hội đểhỗ trợ phòng chống lao; chủ yếu dựa vào cộng đồng và được mạng lưới phòng chống lao và bệnh phổi từ trung ương đến địa phương thực hiện, có sự phối hợp giữa các cơ sở y tế công lập và ngoài công lập. Ngày 17/3/2014, Thủ tướng Chính phủ đã ban hành Quyết định số374/QĐ-TTg phê duyệt Chiến lược quốc gia phòng chống lao đến năm 2020 và tầm nhìn 2030.

Các test phát hiện bệnh lao (TB) đơn giản và sẵn có
Các mục tiêu chiến lược
Mục tiêu hết năm 2015 giảm số người mắc bệnh lao trong cộng đồng xuống dưới 187 người trên 100.000 người dân; giảm số người chết do bệnh lao xuống dưới 18 người trên 100.000 người dân; tỷ lệ mắc lao đa kháng thuốc dưới 5% trong tổng số người bệnh lao mới phát hiện.Mục tiêu hết năm 2020 giảm số người mắc bệnh lao trong cộng đồng xuống dưới 131 người trên 100.000 người dân; giảm số người chết do bệnh lao xuống dưới 10 người trên 100.000 người dân; khống chế số người mắc bệnh lao đa kháng thuốc với tỷ lệ dưới 5% trong tổng số người bệnh lao mới phát hiện. Tầm nhìn đến năm 2030 tiếp tục giảm số người chết do bệnh lao và giảm số người mắc bệnh lao trong cộng đồng xuống dưới 20 người trên 100.000 người dân, hướng tới mục tiêu để người dân Việt Nam được sống trong môi trường không còn bệnh lao.

WHO/C. Doan
Các giải pháp
Giải pháp chính sách, pháp luật bao gồm rà soát, sửa đổi và bổ sung các chính sách phù hợp với thực tiễn công tác phòng chống bệnh lao; nghiên cứu ban hành văn bản quy phạm pháp luật về khuyến khích các tổ chức, cá nhân trong và ngoài nước tham gia vào công tác phòng chống bệnh lao; xây dựng chế độ chính sách ưu đãi cho cán bộ, viên chức, người lao động trong các cơ sở y tế đang làm công tác phòng chống bệnh lao; nghiên cứu ban hành quy định để người có thẻ bảo hiểm y tế được thuận lợi trong khám, chữa bệnh lao cũng như ưu đãi trong chi trả chi phí khám, chữa bệnh lao từ Quỹ bảo hiểm y tế. Giải pháp truyền thông bao gồm đẩy mạnh phổ biến, tuyên truyền pháp luật, chính sách về phòng chống bệnh lao; tuyên truyền về bệnh lao và phòng chống lao để người dân, đặc biệt người dân vùng sâu, vùng xa, người di biến động hiểu, không mặc cảm kỳ thị đối với bệnh lao và chủ động tiếp cận sử dụng dịch vụ khám phát hiện, chẩn đoán, điều trị và dự phòng bệnh lao do ngành y tế cung cấp; các cơ quan, tổ chức, cộng đồng, người bệnh, người nhà người bệnh tham gia tích cực vào tuyên truyền về bệnh lao để mọi tầng lớp nhân dân hiểu và chủ động phòng chống bệnh lao; xây dựng chính sách khuyến khích cộng đồng xã hội tham gia truyền thông giáo dục sức khỏe về phòng chống bệnh lao.

Đào tạo tăng cường năng lực thực hiện nghiên cứu triển khai phòng chống lao tại Việt Nam
Giải pháp chuyên môn kỹ thuật vàdịch vụ phòng chống bệnh lao bao gồm tăng cường phát hiện lao sớm và điều trị có hiệu quả bệnh lao (các cơ sở y tế có trách nhiệm cung cấp dịch vụ khám phát hiện, chẩn đoán, điều trị, dự phòng và quản lý bệnh lao theo hướng dẫn của Bộ Y tế. Các cơ sở y tế chuyên khoa lao và bệnh phổi các tuyến chủ trì, phối hợp với các cơ sở y tế đa khoa, chuyên khoa khác và y tế ngoài công lập bảo đảm hướng dẫn, giám sát việc cung cấp dịch vụ khám phát hiện, chẩn đoán, điều trị và dự phòng bệnh lao có chất lượng cho mọi người dân; nghiên cứu, ban hành chính sách nhằm tạo điều kiện thuận lợi để người dân, đặc biệt người dân vùng sâu, vùng xa, người di biến động dễ dàng tiếp cận và sử dụng dịch vụ khám phát hiện, chẩn đoán, điều trị, dự phòng bệnh lao với khuyến khích tham gia của cộng đồng và các tổ chức xã hội hỗ trợ cho người bệnh lao được sử dụng dịch vụ khám, chữa bệnh lao thuận lợi); đẩy mạnh việc áp dụng các kỹ thuật mới vào khám phát hiện, chẩn đoán, điều trị và dự phòng bệnh lao (xây dựng kế hoạch để chủ động tiếp cận các kỹ thuật đã được WHO khuyến cáo sử dụng nhằm phổ cập dịch vụ khám phát hiện, điều trị và dự phòng bệnh lao toàn diện cũng như sử dụng tối ưu các kỹ thuật truyền thống để khám, chữa và phòng bệnh lao đạt hiệu quả trong điều kiện Việt Nam; nghiên cứu, triển khai thí điểm áp dụng các mô hình tiếp cận mới trước khi triển khai phổ cập các dịch vụ phòng, chốnglao cho người dân thông qua hệ thống y tế công lập và ngoài cônglập với sự tham gia của các tổ chức, đoàn thể và cộng đồng. Thường xuyên rà soát, đánh giá các mô hình đã được thí điểm, nếu có hiệu quả cao, chủ động triển khai nhân rộng nhằm tăng khả năng cung ứng dịch vụ cũng như tạo điều kiện để người dân tiếp cận với các dịch vụ khám, chữa bệnh lao có chất lượng hơn).

Chẩn đoán phát hiện, quản lý và điều trị dứt điểm bệnh lao tại các cơ sở tế chuyên khoa
Giải pháp hợp tác quốc tế bao gồm củng cố và tăng cường hợp tác với các nước, tổ chức, cá nhân nước ngoài về lĩnh vực nghiên cứu, thử nghiệm lâm sàng và hỗ trợ kỹ thuật phòng chống lao, đặc biệt với các tổ chức đã có mối quan hệ lâu dài và có kỹ thuật phòng, chống lao tiên tiến; mở rộng hợp tác quốc tế trong các lĩnh vực của công tác phòng chống lao, tích cực và chủ động vận động sự hỗ trợ của các tổ chức quốc tế cho các lĩnh vực đột phá trong công tác phòng chống lao; hợp tác chặt chẽ với các nước trong khu vực và thế giới để cùng giải quyết vấn đề phát hiện, điều trị và lan truyền bệnh lao qua biên giới cũng như các đối tượng di biến động. Giải pháp về cung ứng thuốc và hậu cần kỹ thuật phòng chống bệnh lao bao gồm nghiên cứu, xây dựng và hoàn thiện cơ chế quảnlý, cung ứng thuốc chữa bệnh lao và hậu cần kỹ thuật phù hợp cho công tác phòng, chống bệnh lao kịp thời; nghiên cứu, ban hành chính sách tạo điều kiện tốt hơn về dinh dưỡng cho bệnh nhân lao; củng cố và tăng cường cơ sở hạ tầng, trang thiết bị y tế cho các cơ sở y tế trong việc tham gia phát hiện, chẩn đoán và điều trị bệnh lao; đầu tư nghiên cứu sản xuất thuốc trong nước đáp ứng nhu cầu điều trị cho người bệnh lao, theo dõi tình hình kháng thuốc và phản ứng có hại của thuốc điều trị bệnh lao. Giải pháp về nguồn tài chính cho công tác phòng chống bệnh lao bao gồm nguồn kinh phí phòng chốnglao được cấp từ ngân sách nhà nước theo quy định của pháp luật ngân sách nhà nước, nguồn Quỹ bảo hiểm y tế, các nguồn tài trợ của các tổ chức, cá nhân trong và ngoài nước và các nguồn vốn hợp pháp khác. Giải pháp về nguồn nhân lực cho công tác phòng chống lao bao gồm nghiên cứu ban hành chính sách ưu tiên về đào tạo, tuyển dụng, sử dụng và đãi ngộ đối với cán bộ, viên chức và người lao động làm công tác phòng chống lao; đa dạnghóacác loại hình đào tạo chuyên khoa, cập nhật kiến thức phòng chống bệnh lao cho các thầy thuốc đa khoa và chuyên khoa khác; kết hợp hình thức đào tạo tập trung với đào tạo tại chức, đào tạo ngắn hạn và dài hạn; bồi dưỡng y khoa liên tục thông qua tập huấn, hội nghị, hội thảo, hướng dẫn trực tiếp; nâng cao năng lực quản lý về phòng chống bệnh lao cho cán bộ quản lý các cấp thông qua các chương trình đào tạo, tham quan học tập, chia sẻ kinh nghiệm trong và ngoài nước; lồng ghép hoạt động phòng chống bệnh lao với hoạt động phòng, chống HIV/AIDS, các bệnh phổi mạn tính và các hoạt động y tế dự phòng khác. Giải pháp về kiểm tra giám sát bao gồm đẩy mạnh hoạt động và hoàn thiện việc theo dõi, báo cáo để lượng giá, đánh giá và kiểm soát chất lượng dịch vụ phòng chống bệnh lao ở tất cả các cơ sở y tế bằng áp dụng công nghệ thông tin; nghiên cứu xây dựng kế hoạch nhằm nâng cao nănglực giám sát dịch tễ bệnh lao và đánh giá hiệu quả công tác phòng chống bệnh lao các tuyến thông qua các chương trình đào tạo, tham quan học tập, chia sẻ kinh nghiệm trong và ngoài nước; tăng cường công tác kiểm tra giám sát việc thực hiện chính sách pháp luật về phòng chống lao.

Tuyên truyền phòng chống bệnh lao ở Việt Nam
Hỗ trợ của WHO cho phòng chống bệnh lao ở Việt Nam
WHO cung cấp hỗ trợ kỹ thuật cho Chương trình Chống lao Quốc gia Việt Nam từ năm 2002 đối với tất cả các hợp phần của chiến lược chống lao toàn cầu như tiếp tục mở rộng và tăng cường DOTS chất lượng cao (pursue high-quality DOTS expansion and enhancement); giải quyết lao/HIV, lao kháng đa thuốc và nhu cầu của người nghèo và các nhóm dân cư dễ bị tổn thương (Address TB-HIV, multi-drug resistant (MDR) tuberculosis, and the needs of poor and vulnerable populations); góp phần củng cố hệ thống y tế dựa trên hệ thống chăm sóc sức khỏe ban đầu (contribute to health system strengthening based on primary health care); thu hút sự tham gia của tất cả các nhà cung cấp dịch vụ (engage all care providers); trao quyền cho bệnh nhân lao và cộng đồng thông qua các quan hệ đối tác (empower people with TB and communities through partnerships); khuyến khích và thúc đẩy nghiên cứu (enable and promote research). WHO tham gia xây dựng Kế hoạch phát triển trung hạn (Mid-term development plan) giai đoạn 2007-2011 và Kế hoạch chiến lược quốc gia (National strategic plan) giai đoạn 2011-2015, đồng thời đề xuất dự án thành công lên Quỹ Toàn cầu phòng chống AIDS, Lao và Sốt rét (Global Fund for AIDS, Tuberculosis and Malaria _GFATM). WHO đang hỗ trợ cho Ban điều hành các đối tác phòng chống lao (Stop TB Partnership) Việt Nam-một tổ chức tự nguyện của các đối tác thuộc khu vực công, xã hội dân sự và khu vực tư nhân/doanh nghiệp cam kết phối hợp hành động để phòng ngừa, chăm sóc và kiểm soát bệnh lao.

Tài liệu tư vấn phòng chống bệnh lao
Mặc dù có nhiều nỗ lực nhưng những thách thức đang là trở ngại lớn cho Chiến lược chấm dứt bệnh lao nhưhệ thốngy tế yếu kém, nguồn nhân lực và tài chính hạn chế,đại dịchđồngnhiễm nghiêm trọngvới HIV,bệnhđái tháo đường vàhútthuốc lá; cùng với đó MDR-TB là một thách thứcnghiêmtrọngkhác, hành động khẩn cấp và hiệu quả để giải quyết vấn đề kháng với thuốc kháng sinh là chìa khóa nhằm chấm dứt bệnh lao vào năm 2030 vì vậy các khoản đầu tư cần được tăng lên do sự đáp ứng toàn cầu với bệnh lao vẫn thiếu thốn nguồn vốn cho cả việc thực hiện và nghiên cứu. WHO cam kết tiếp tục công việc của mình với các nước và các đối tác trên toàn thế giới, trong đó có Việt Nam để giải quyết những thách thứcnàyvà thúc đẩy hành động tập thểnhằmchấm dứt dịch bệnh lao hoàn toàn. Chiến lược xóa bỏ bệnh lao trong phạm vi quốc gia cũng như quốc tế nhiều tham vọng, trong bối cảnh phòng chống bệnh lao còn nhiều thách thức như vậy nên WHO cho rằng hợp tác lớn hơn là cần thiết (greater collaboration needed). Chấm dứt TB sẽ chỉ đạt được với sự hợp tác lớn hơn giữa các chính phủ và đối tác xã hội dân sự, cộng đồng, nhà nghiên cứu, khu vực tư nhân và các cơ quan phát triển nghĩa là cần có sự tiếp cận của toàn xã hội và đa ngành, trong bối cảnh bảo hiểm y tế toàn dân với những tiến bộ ở 30 quốc gia có gánh nặng bệnh lao cao hơn85% gánh nặng toàn cầu; một số quốc gia đang tăng cường các chương trình nghị sự chiến lược của chương trình lao bằng cách áp dụng các công cụ mới, mở rộng tiếp cận chăm sóc và liên kết với các ngành khác của chính phủ để làm giảm chi phí tài chính phát sinh cho bệnh nhân; một sốquốc gia khác đang hợp tác với các nhà nghiên cứu nhằm gia tăng tốc độ phát triển các xét nghiệm chẩn đoán, các loại thuốc, vaccine và cải thiện sự phân phối.

TS. Margaret Chan, Tổng Giám đốc WHO phát biểu các quốc gia cần nỗ lực tiến tới xóa bỏ bệnh lao
Hướng tới các Mục tiêu phát triển bền vững (SDGs), tại kỳ họp của Đại Hội đồng Y tế thế giới (WHA) và Đại hội đồng Liên Hợp Quốc (UNGA) các chính phủ đồng ý về mục tiêu chiến lược chấm dứt dịch bệnh lao của WHO. TS. Margaret Chan, Tổng Giám đốc WHO phát biểu: "Chúng ta đang phải đối mặt với cuộc chiến đầy khó khăn để đạt được mục tiêu toàn cầu chấm dứt bệnh lao, các quốc gia cần có những nỗ lực ở quy mô lớn hơn hoặc tiếp tục tụt hậu sau dịch bệnh chết người này cùng những mục tiêu tham vọng bịbỏ qua". Thanh toán bệnh lao vào năm 2030 là một trong những mục tiêu sức khỏe của SDGs mới được thông qua, WHO cùng các quốc gia thành viên đã tiến một bước xa hơn và thiết lập mục tiêu giảm tử vong 95% và giảm tỷ lệ nhiễm lao 90% tiến tới chấm dứt hoàn toàn bệnh lao vào năm 2035.